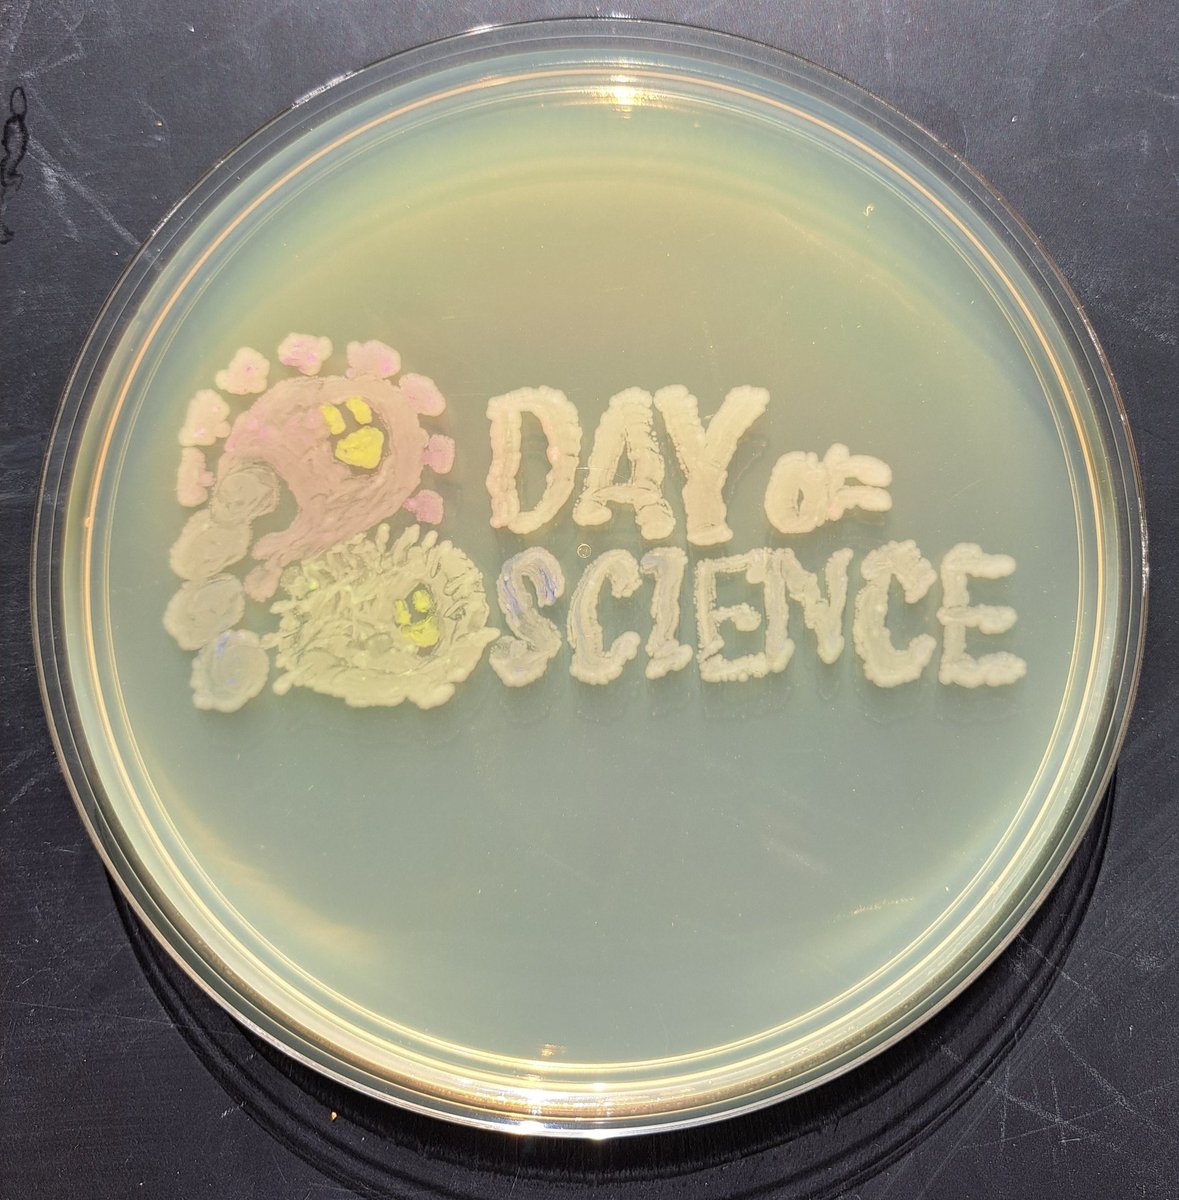
GermJuggler's tweet image. Preparing for #ASMicrobe and #DayOfScience on Saturday. Bringing some #AgarArt with me just for fun. Join us on Saturday if you are in town. Saturday June 17 from 12 to 4. Lott Hall at Hermann Park in Houston @ASMicrobiology
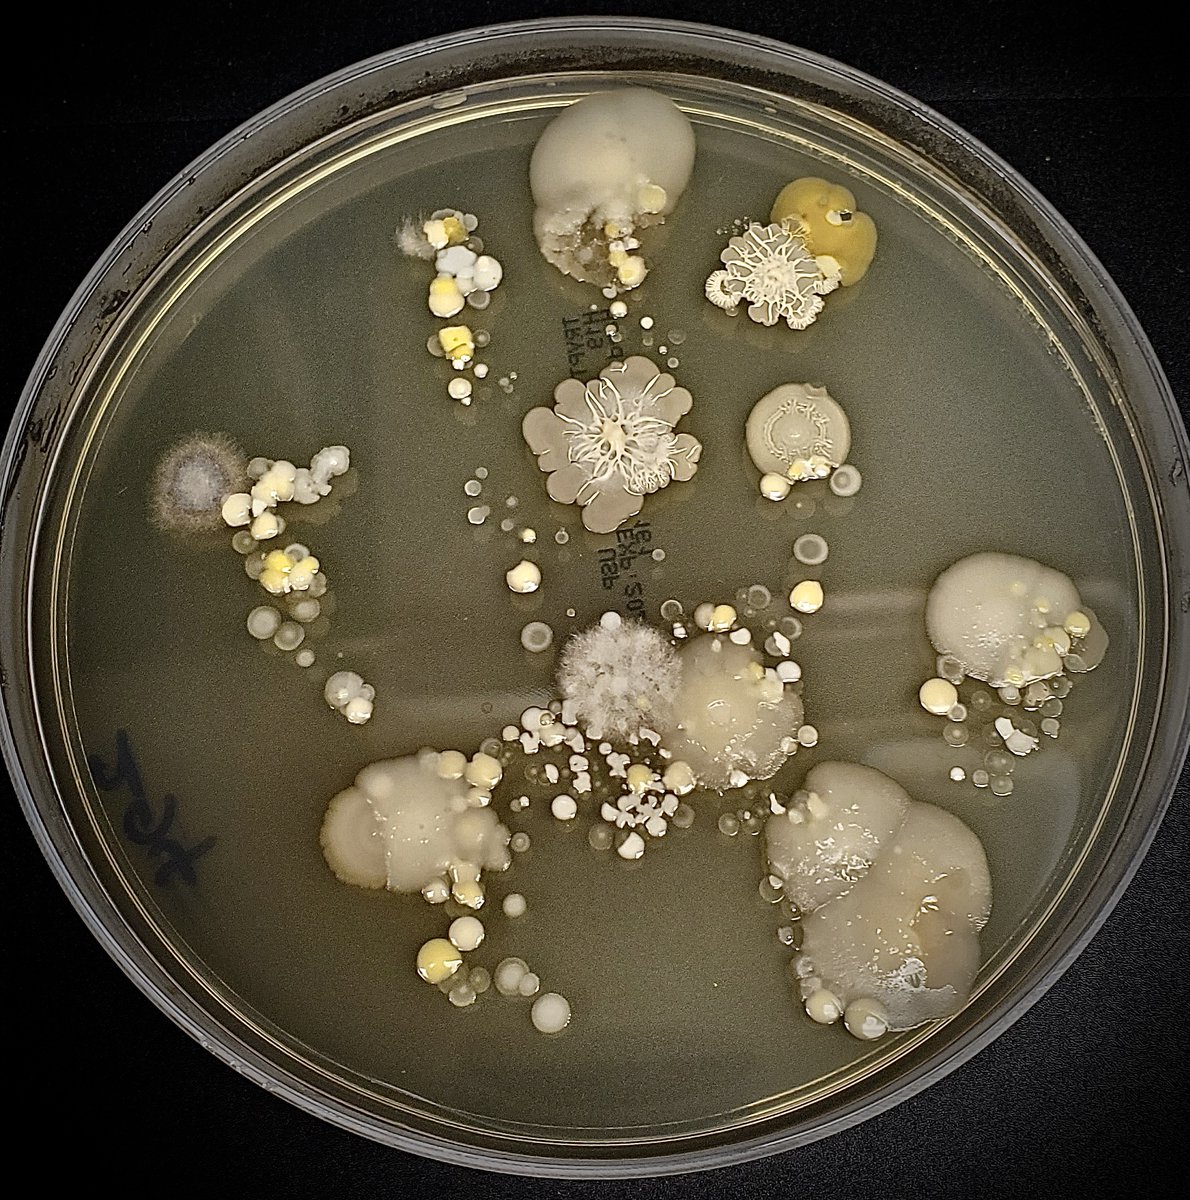
tasturm1's tweet image. #DescribeThatMicrobe Results from our #DayOfScience in Houston and lots of #Handprints. Here is a sampling....thanks to @asm_tmc and especially @alexdh_kang for all their hard work! @ASMicrobiology @TheGeoffHunt
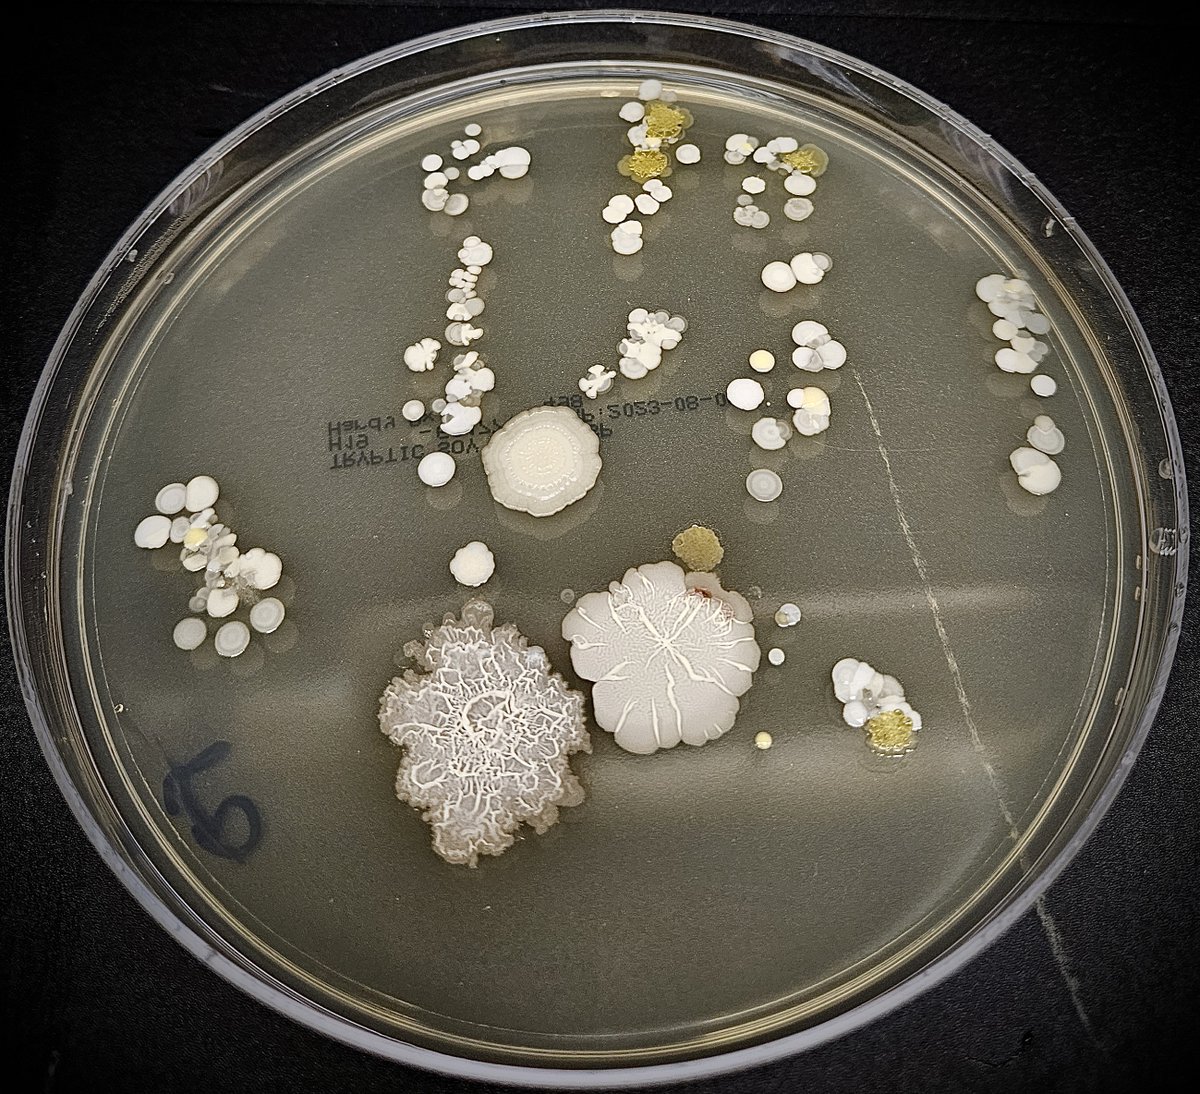
tasturm1's tweet image. #DescribeThatMicrobe Results from our #DayOfScience in Houston and lots of #Handprints. Here is a sampling....thanks to @asm_tmc and especially @alexdh_kang for all their hard work! @ASMicrobiology @TheGeoffHunt

#dayofscience search results
Join us in Houston on June 17 for our first ever #DayofScience! Come get your hands dirty with free #STEM activities presented by: 💠@cmhouston 💠@edvotek 💠@HardyDiagnostic 💠@hmns 💠@HoustonHumane 💠@LPItoday 💠And more! Get your tickets now! asm.social/1g9
eventbrite.com
Day of Science
A free science festival for the local Houston community.
Scientific discovery doesn't happen in a vacuum - actual humans are involved! Time not spent with my sons has to be worthwhile & that's why I work on #AirQuality & #climate. #DayOfScience

#DayOfScience 44,000 words down for the first draft of my book on practical innovation; 9 chapters in total: 4 complete, 3 under major revision, 2 outlined For the record a non-fiction memoir how-to book should be about 50k-75k words. It's a marathon; how about a #writerslift?
On my #DayofScience, I’m celebrating finishing my final big milestone for the semester- submitting my GRFP! Here are some photos of what I’ve been up to this semester!




My #DayOfScience started with one of the best parts of the job, listening to a fantastic Ph.D. defense. Anna Hermes did an excellent, comprehensive and important set of studies on sulfur in agricultural systems! Congrats Anna, well done!

#DayofScience working from home today. Will join the Department Chairs and Institute Directors meeting with the Provost- and then meet to discuss updates to our career track in #CIRES- making our organization better. Got a great walk in out this morning!

Getting ready for #ASMicrobe in two weeks. Excited to be participating in #DayOfScience on Saturday, June 17. I'll be bringing one of my favorite activities - #WhatMicrobeAreYou If you're in Houston come by and check it out. @ASMicrobiology @MissouriSandT @SandTKummerSTEM


#DescribeThatMicrobe Results from our #DayOfScience in Houston and lots of #Handprints. Here is a sampling....thanks to @asm_tmc and especially @alexdh_kang for all their hard work! @ASMicrobiology @TheGeoffHunt




Did you say t-shirt?! Go register for the @science_a_thon #dayofscience!
We now have over 100 participants for this year's event!! 🎉🎉 We welcome registrations anytime between now and the end of Science-A-Thon in October. But register today if you want to make sure your t-shirt gets to you before the event! scienceathon.org/participate
Webinar #2! Annual pesticide training for public health, those who control mosquitoes and West Nile Virus in SD. I will talk about climate this season, outlook for winter and spring, and weather tools for effective pesticide application #scicomm #DayOfScience #ScienceAThon

Ever wondered who are these people w/ posters or poster tubes at airports? Well, guess what, they're scientists! 😄 #dayofscience

What does a scientist look like? This is what a scientist looks like! I love being able to wear whatever I want to my classes. First pic I took today, the others are all from the past few weeks. #DayofScience #ScienceAThon @science_a_thon




Hi everyone! 👋 My name is Leon Chew (@chewonleon), I’m a Scientist on the Neural team, and I am taking over STEMCELL’s Twitter account today as part of the @science_a_thon. #DayOfScience Follow along to see what it’s like working as an R&D Scientist! 👇

Join the countdown to Science-a-thon to share your #DayOfScience Learn more an register today: scienceathon.org

Today I will be participating in @science_a_thon and will document my #DayOfScience at @SaltLakeCC !

Yesterday was a busy #dayofscience, starting out pretty normal (except I don't normally take selfies in the bathroom mirror!)

1/ My day always starts with a wake-up summons from my 15-month son 😆The later sunrises have been helping him sleep in a bit 👌 Shortly thereafter, a dog jumps on my face. Time for a dog walk! #dayofscience

#DayOfScience throwback - Science Communication is key! Sometime as scientists we get to talk with different groups about the science we are doing and why it is important. Here is a shot from a visit to the Hill (many years ago) with @jf_lamarque @science_a_thon

Graduate student recruiting on this #dayofscience #DayOfTheGirl in the time of #COVID19 Me: GMT-5 Sukriti: GMT+5.5 Our schedules: GMT-8

Hard to capture what even one #dayofscience looks like for @science_a_thon. Every hr different! Today, rare in-person chances to teach & meet with research students. Yesterday, checking #covidCO2 sensors to monitor ventilation 👇. The variety is the fun (& crazy) part of the job.

🎉 Celebrating the first-ever Day of Science in Slovenia – a tribute to knowledge, research & innovation! 🔬📚 At thUM FHS, we proudly join all research partners in honoring scientists and their vital role in society. 💡 #DayOfScience #Research #Innovation #Knowledge

Everyone is welcome to join! 📅 Save the Date: 26/11/2023 🕒 Time: 10:00-17:00 📍 Location: Celestijnenlaan 300, 3001 Heverlee 🔗No registration is required. @KU_Leuven #DVDW2023 #DayOfScience #Science #Innovation #Event #LMSD #KULeuven #FlandersMake
🎉🔬 Celebrating the National Day of Nikola Tesla - Day of Science! 🌟⚡️ #NikolaTeslaDay #DayofScience #ScientificInnovation #CuriosityUnleashed #FutureScientists #KTGlobalSchool #KTGS #TransformingMinds

#DescribeThatMicrobe Results from our #DayOfScience in Houston and lots of #Handprints. Here is a sampling....thanks to @asm_tmc and especially @alexdh_kang for all their hard work! @ASMicrobiology @TheGeoffHunt




A fun afternoon participating in #DayOfScience during #ASMicrobe. Great turnout and lots of great activities. Bioluminescence didn't go as well as planned but still had a great time talking to kids of all ages about microbes. @ASMicrobiology




Preparing for #ASMicrobe and #DayOfScience on Saturday. Bringing some #AgarArt with me just for fun. Join us on Saturday if you are in town. Saturday June 17 from 12 to 4. Lott Hall at Hermann Park in Houston @ASMicrobiology

Join us in Houston on June 17 for our first ever #DayofScience! Come get your hands dirty with free #STEM activities presented by: 💠@cmhouston 💠@edvotek 💠@HardyDiagnostic 💠@hmns 💠@HoustonHumane 💠@LPItoday 💠And more! Get your tickets now! asm.social/1g9
eventbrite.com
Day of Science
A free science festival for the local Houston community.
Getting ready for #ASMicrobe in two weeks. Excited to be participating in #DayOfScience on Saturday, June 17. I'll be bringing one of my favorite activities - #WhatMicrobeAreYou If you're in Houston come by and check it out. @ASMicrobiology @MissouriSandT @SandTKummerSTEM


Yesterday, we hosted our "Day of Science" with BU Stem Pathways at our learning lab! We are so happy to see the collaboration and innovation that comes from a room of scientists. #biobuilder #wherescientistsgrow #dayofscience



#DayofScience in #Kazakhstan related with outstanding geologist Kanysh Satbayev. March1947, soviet delegation in London, #Winston Churchill asked Satbayev jokingly: -If all kazakhs are such stately and tall men like you? -No. My people are much higher then me, said Satbayev.

Excited about our #DayofScience @Highview6th tomorrow ! Students will focus on science the entire day thank you @quest_church for making this happen for our students! #MiddieRising #AimHIGHview
It's never too early to plan #summerActivities for the kids! Check out what #science-oriented hands-on @ASMicrobiology offers. #DayofScience @BCMGradSchool @BCMHouston_News
Know kids that love #science and looking 👀 for summer activities?!?! Come out and enjoy a #DayofScience put on by the @ASMicrobiology - Meet actual #Scientists and get hands-on exposure to the world of #Microbiology

Really looking forward to this session! Pharmacists can have a huge impact on disparities, equity, and access! #APhA2023 #DayofScience

Know kids that love #science and looking 👀 for summer activities?!?! Come out and enjoy a #DayofScience put on by the @ASMicrobiology - Meet actual #Scientists and get hands-on exposure to the world of #Microbiology

The future is ✨bright✨for #womeninSTEM and for #whitebark! Grateful to @GSMWcouncil and Montana Science Center for featuring whitebark pine as part of their #DayOfScience. #inspired #savethewhitebarkpine
Today over 50 Girl Scouts of @GSMWcouncil promised to plant and protect trees to make their world a better place. Go Girl Scouts! @AmericanForests is proud to be your #GirlScoutTreePromise partner! @girlscouts @EPansing #SaveTheWhitebarkPine

Kicked off the end of #ScienceAThon week with #EarlyVoting + our tradition of getting breakfast together after. (We got our @HelloBagelBburg fix!) Virginia is doing a good job with voting options; glad to live in a place that tries to increase voter turnout. #dayofscience #VOTE

Hello! Today is my #dayofscience for #ScienceAThon. I'm an assistant prof @ Colorado College. We teach on the Block schedule (3.5 weeks of class, one class at a time). Today is the last day of class - full of presentations, a faculty meeting, and diving back into research!

My #DayOfScience started with one of the best parts of the job, listening to a fantastic Ph.D. defense. Anna Hermes did an excellent, comprehensive and important set of studies on sulfur in agricultural systems! Congrats Anna, well done!

On my #DayofScience, I’m celebrating finishing my final big milestone for the semester- submitting my GRFP! Here are some photos of what I’ve been up to this semester!




Ending the last #DayOfScience at our local farmers market signing copies of my book #TheWeatherStory. I hope you've enjoyed this week long look into how I use #Science thanks to @science_a_thon

Ever wondered who are these people w/ posters or poster tubes at airports? Well, guess what, they're scientists! 😄 #dayofscience

Thanks to all who have already signed up for @science_a_thon! Sign-ups welcome anytime, but register this week to get a t-shirt in time for your #dayofscience! Whether you're participating for fun, or as #scicomm for #STEM #outreach scienceathon.org

Good morning and welcome to my #DayOfScience! This is exactly how I started it last year... jumping out of bed and logging in to check on my GC-IRMS run from overnight. This time I’m measuring the very first δD values from a new project! I have a packed day, so stay tuned!

No photos at the office today for @science_a_thon #DayOfScience , #NewChairLife Monday’s (well the whole week…) are often admin meeting and email heavy, but I do like to come home to this 🥔 at the end (though a dinner mtg awaits…)

Today is my only “normal” #dayofscience this week. I usually bike or take the bus to work. Because the weather is nice and winter is coming, today I biked! I used a shared bike from @Boulder_Bcycle!

More on the 2005 #HurricaneWilma on this @UWCIMSS Satellite Blog cimss.ssec.wisc.edu/satellite-blog… by @CIMSS_Satellite. @NOAASatellites #GOES12 visible loop: cimss.ssec.wisc.edu/satellite-blog… @UWSSEC #dayofscience @science_a_thon
#SATELLITE SPOTLIGHT: #OnThisDay in 2005, #Wilma became a #hurricane as @NOAA's #GOES-12 watched from above. After rapidly intensifying, Wilma became a Category-5 storm on October 19 and still holds the record for the most intense tropical cyclone in the Atlantic basin.
Hi everyone! 👋 My name is Leon Chew (@chewonleon), I’m a Scientist on the Neural team, and I am taking over STEMCELL’s Twitter account today as part of the @science_a_thon. #DayOfScience Follow along to see what it’s like working as an R&D Scientist! 👇

Excited to start the @science_a_thon this week! On my first #DayOfScience, I have a meeting with a colleague, four student appointments, and I’m presenting on a faculty panel for MNSU for their Bringing Research into the Classroom Certificate program - & that’s all before lunch!

Webinar #2! Annual pesticide training for public health, those who control mosquitoes and West Nile Virus in SD. I will talk about climate this season, outlook for winter and spring, and weather tools for effective pesticide application #scicomm #DayOfScience #ScienceAThon

We are getting close to 75 registrants for this year's event. Join these scientists in sharing a #dayofscience this October! Fun, easy, and only $25 - plus you get a super cool t-shirt! scienceathon.org/participate

#DescribeThatMicrobe Results from our #DayOfScience in Houston and lots of #Handprints. Here is a sampling....thanks to @asm_tmc and especially @alexdh_kang for all their hard work! @ASMicrobiology @TheGeoffHunt

It’s the final day of the @science_a_thon #DayOfScience! Today it starts w/ an early morning workout. This time to and for myself, before the house comes to life, sets a positive stage for the rest of the day. #LegDay #DoYourBest #ForgetTheRest

#DayofScience in #Kazakhstan related with outstanding geologist Kanysh Satbayev. March1947, soviet delegation in London, #Winston Churchill asked Satbayev jokingly: -If all kazakhs are such stately and tall men like you? -No. My people are much higher then me, said Satbayev.

Today is #ScienceAThon Friday and posting about my #dayofscience in support of @ESWNtweets Days are more home bound under COVID but I have my coffee and science assistant at hand.


Something went wrong.
Something went wrong.
United States Trends
- 1. #SmackDown N/A
- 2. Duke N/A
- 3. #DragRace N/A
- 4. Sami N/A
- 5. Sami N/A
- 6. Michigan State N/A
- 7. Tiger N/A
- 8. Jelly Roll N/A
- 9. UConn N/A
- 10. Mania N/A
- 11. #OPLive N/A
- 12. Caleb Foster N/A
- 13. Prey N/A
- 14. Thune N/A
- 15. #TNASacrifice N/A
- 16. #GoBlue N/A
- 17. Alabama N/A
- 18. Alex Freeland N/A
- 19. Coen Carr N/A
- 20. Jane Don't N/A




















































